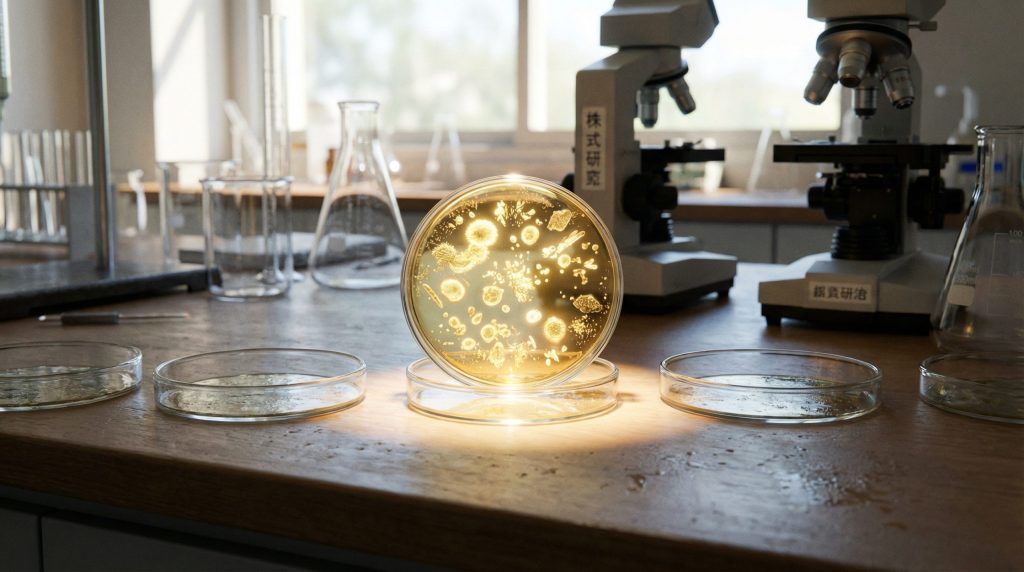
自社に最適な受託企業の選び方

細胞培養の受託サービス完全ガイド|選び方から流れまで解説
再生医療事業の立ち上げを任されたものの、「専門的な設備や知識がなくてどうしよう……」と頭を抱えていませんか?
細胞培養には高度な技術と厳格な管理が求められるため、すべてを自社で賄うのは大変なハードルですよね。そんな時に頼りになるのが「細胞培養 受託サービス」です。
この記事では、専門知識が少ない方でも安心して事業を進められるよう、受託サービスの仕組みやメリット、そして失敗しないパートナーの選び方をやさしく解説します。自社にぴったりの方法を見つけて、スムーズな事業化を目指しましょう。
細胞培養受託サービスとは?仕組みと背景

細胞培養受託サービスとは、簡単に言えば「細胞を育てる工程をプロにお任せする」サービスのことです。
自社で莫大な設備投資をしなくても、高度な技術を持つ専門機関が代わりに培養や加工を行ってくれます。まずは、具体的にどこまでお願いできるのか、そしてなぜ今このサービスが注目されているのかを見ていきましょう。
外部委託できる業務内容と範囲
受託サービスでお願いできる範囲は、想像以上に幅広いものです。単に細胞を増やすだけでなく、以下のような一連のプロセスを委託できることが多いですね。
- 細胞の分離・抽出: 組織から目的の細胞を取り出す
- 培養・拡大: 細胞を必要な数まで増やす
- 品質管理・検査: 安全性や品質をチェックする
- 凍結保存: 将来の使用に備えて保管する
研究段階の小規模なものから、患者さんに投与するための臨床用グレード(安確法の基準、場合によってはGCTP準拠)まで、目的に応じて柔軟に対応してもらえるのが特徴です。まずは「やりたいこと」を相談してみると良いでしょう。
なぜ今、細胞培養のアウトソーシングが増えているのか
最近、多くの企業がアウトソーシング(外部委託)を選ぶようになっています。その大きな理由は、法規制の厳格化とコストの問題です。
再生医療を行うための法律(再生医療等安全性確保法など)は非常に厳しく、自社で基準を満たす施設(CPC)を作り、維持するには莫大な費用と手間がかかります。また、熟練した培養技術者を確保するのも一苦労ですよね。
「餅は餅屋」という言葉があるように、難しい部分はプロに任せて、自社は企画や臨床応用に集中しようという動きが加速しているのです。
自社培養と比較した際のメリット・デメリット

「全部自分たちでやるべきか、それとも外にお願いするべきか……」ここは事業計画を立てる上で一番悩むポイントではないでしょうか。
受託サービスを利用することは、初期費用を抑えられる一方で、長期的な視点で見ると注意すべき点もあります。それぞれのメリットとデメリットをしっかりと比較して、自社の状況に合った選択をしましょう。
メリット:設備投資コストの削減と法規制対応
最大のメリットは、やはりコストと時間の節約です。自前で細胞培養加工施設(CPC)を建設しようとすると、数千万円から億単位の投資が必要になることも珍しくありません。
受託サービスなら、すでに再生医療等安全性確保法(安確法)や、必要に応じてGCTP省令などの法規制に対応した施設を利用できます。
- 初期投資の削減: 施設建設費や機器購入費が不要
- 法対応の安心感: 厳しい基準をクリアした環境で培養
- スピード: 立ち上げまでの期間を大幅に短縮
専門家が管理する環境でスタートできるので、安心して事業の一歩を踏み出せますね。
デメリット:社内ノウハウの蓄積と長期的なコスト
一方で、デメリットにも目を向けておく必要があります。長く外部に頼り続けると、どうしても社内に技術やノウハウが蓄積されにくくなります。
- 技術の空洞化: 自社スタッフが育ちにくい
- ランニングコスト: 長期的には委託費が割高になる可能性も
- ブラックボックス化: 細かい工程が見えにくくなるリスク
将来的に「やっぱり自社でやりたい」となった時に、ゼロから学ぶことになるかもしれません。事業のフェーズに合わせて、委託と自社化のバランスを検討してみるのがおすすめです。
自社に最適な受託企業の選び方
いざ受託サービスを利用しようと思っても、たくさんの企業があってどこを選べばいいか迷ってしまいますよね。
パートナー選びに失敗しないためには、「安さ」だけで選ばず、技術力やサポート体制をしっかりチェックすることが大切です。ここでは、信頼できる委託先を見極めるための3つのポイントをご紹介します。
実績のある細胞種と技術力を確認する
一口に「細胞培養」と言っても、扱う細胞によって必要な技術は異なります。例えば、脂肪由来幹細胞と免疫細胞では培養のコツが全く違うのです。
検討している企業が、自社が扱いたい細胞種での実績を持っているかを必ず確認しましょう。
- 過去の実績: 具体的な症例数や提携医療機関
- 論文や学会発表: 技術的な裏付けがあるか
ホームページを見るだけでなく、実際に担当者と話して「この細胞の経験はありますか?」と率直に聞いてみるのが一番の近道ですよ。
施設の管理体制と品質保証(バリデーション)
患者さんの体に入る細胞を扱うわけですから、安全性は何よりも重要です。施設がどのように管理されているか、品質保証体制(バリデーション)が整っているかをチェックしましょう。
- 清浄度管理: 無菌操作ができる環境か
- 記録管理: 製造記録や品質試験記録が正しく残されるか
- トレーサビリティ: 細胞の出所や工程が追跡できるか
可能であれば、実際に施設を見学させてもらうのも良い方法です。整理整頓が行き届いている現場は、やはり仕事も丁寧なことが多いものですよ。
開発段階から輸送・申請までのサポート体制
培養技術だけでなく、その前後のサポートも重要です。特に新規参入の場合、厚生労働省への申請手続きや、細胞の輸送方法などでつまずくことがよくあります。
- 申請サポート: 再生医療等提供計画の作成支援など
- 輸送体制: 温度管理された専用車両での輸送
- トラブル対応: 万が一の時のバックアップ体制
「培養して終わり」ではなく、事業全体を伴走してくれるパートナーを選ぶと、その後の運営がぐっと楽になりますよ。
サービス利用の一般的な流れ

実際に受託サービスを利用する場合、どのような流れで進むのでしょうか。一般的なフローを把握しておくと、準備もスムーズに進められます。
多くの企業では、以下のようなステップで進んでいきます。
- お問い合わせ・相談
まずはウェブサイトなどから問い合わせます。希望する細胞の種類や目的(研究用か臨床用か)、スケジュール感を伝えましょう。 - ヒアリング・提案
専門スタッフが詳細を聞き取り、最適なプランや見積もりを提案してくれます。ここで秘密保持契約(NDA)を結ぶこともあります。 - 契約締結
内容に合意したら正式に契約を結びます。 - 細胞・検体の受領
医療機関などで採取された組織や細胞を、専用の輸送手段で受託企業の施設へ運びます。 - 培養・加工・品質試験
CPC内で細胞を培養・加工します。工程の途中で品質チェックも行われます。 - 納品・報告
最終的な品質試験をクリアした細胞製品と、製造記録などの報告書が納品されます。
初めての場合は、最初のヒアリングで不安な点をすべて解消しておくことが成功の鍵です。どんな些細なことでも質問してみてくださいね。
まとめ

細胞培養の受託サービスについて、仕組みや選び方をご紹介しました。
専門的な設備や人材が必要な再生医療事業において、アウトソーシングはリスクを抑えてスピーディーに参入するための賢い選択肢です。
- 初期投資を抑えてスタートできる
- 法規制に対応した高品質な細胞が得られる
- 専門家のサポートで安心して事業を進められる
もちろん、将来的な内製化も視野に入れつつ、まずは信頼できるパートナーを見つけることから始めてみてはいかがでしょうか。あなたの事業が成功し、多くの患者さんの笑顔につながることを応援しています。
